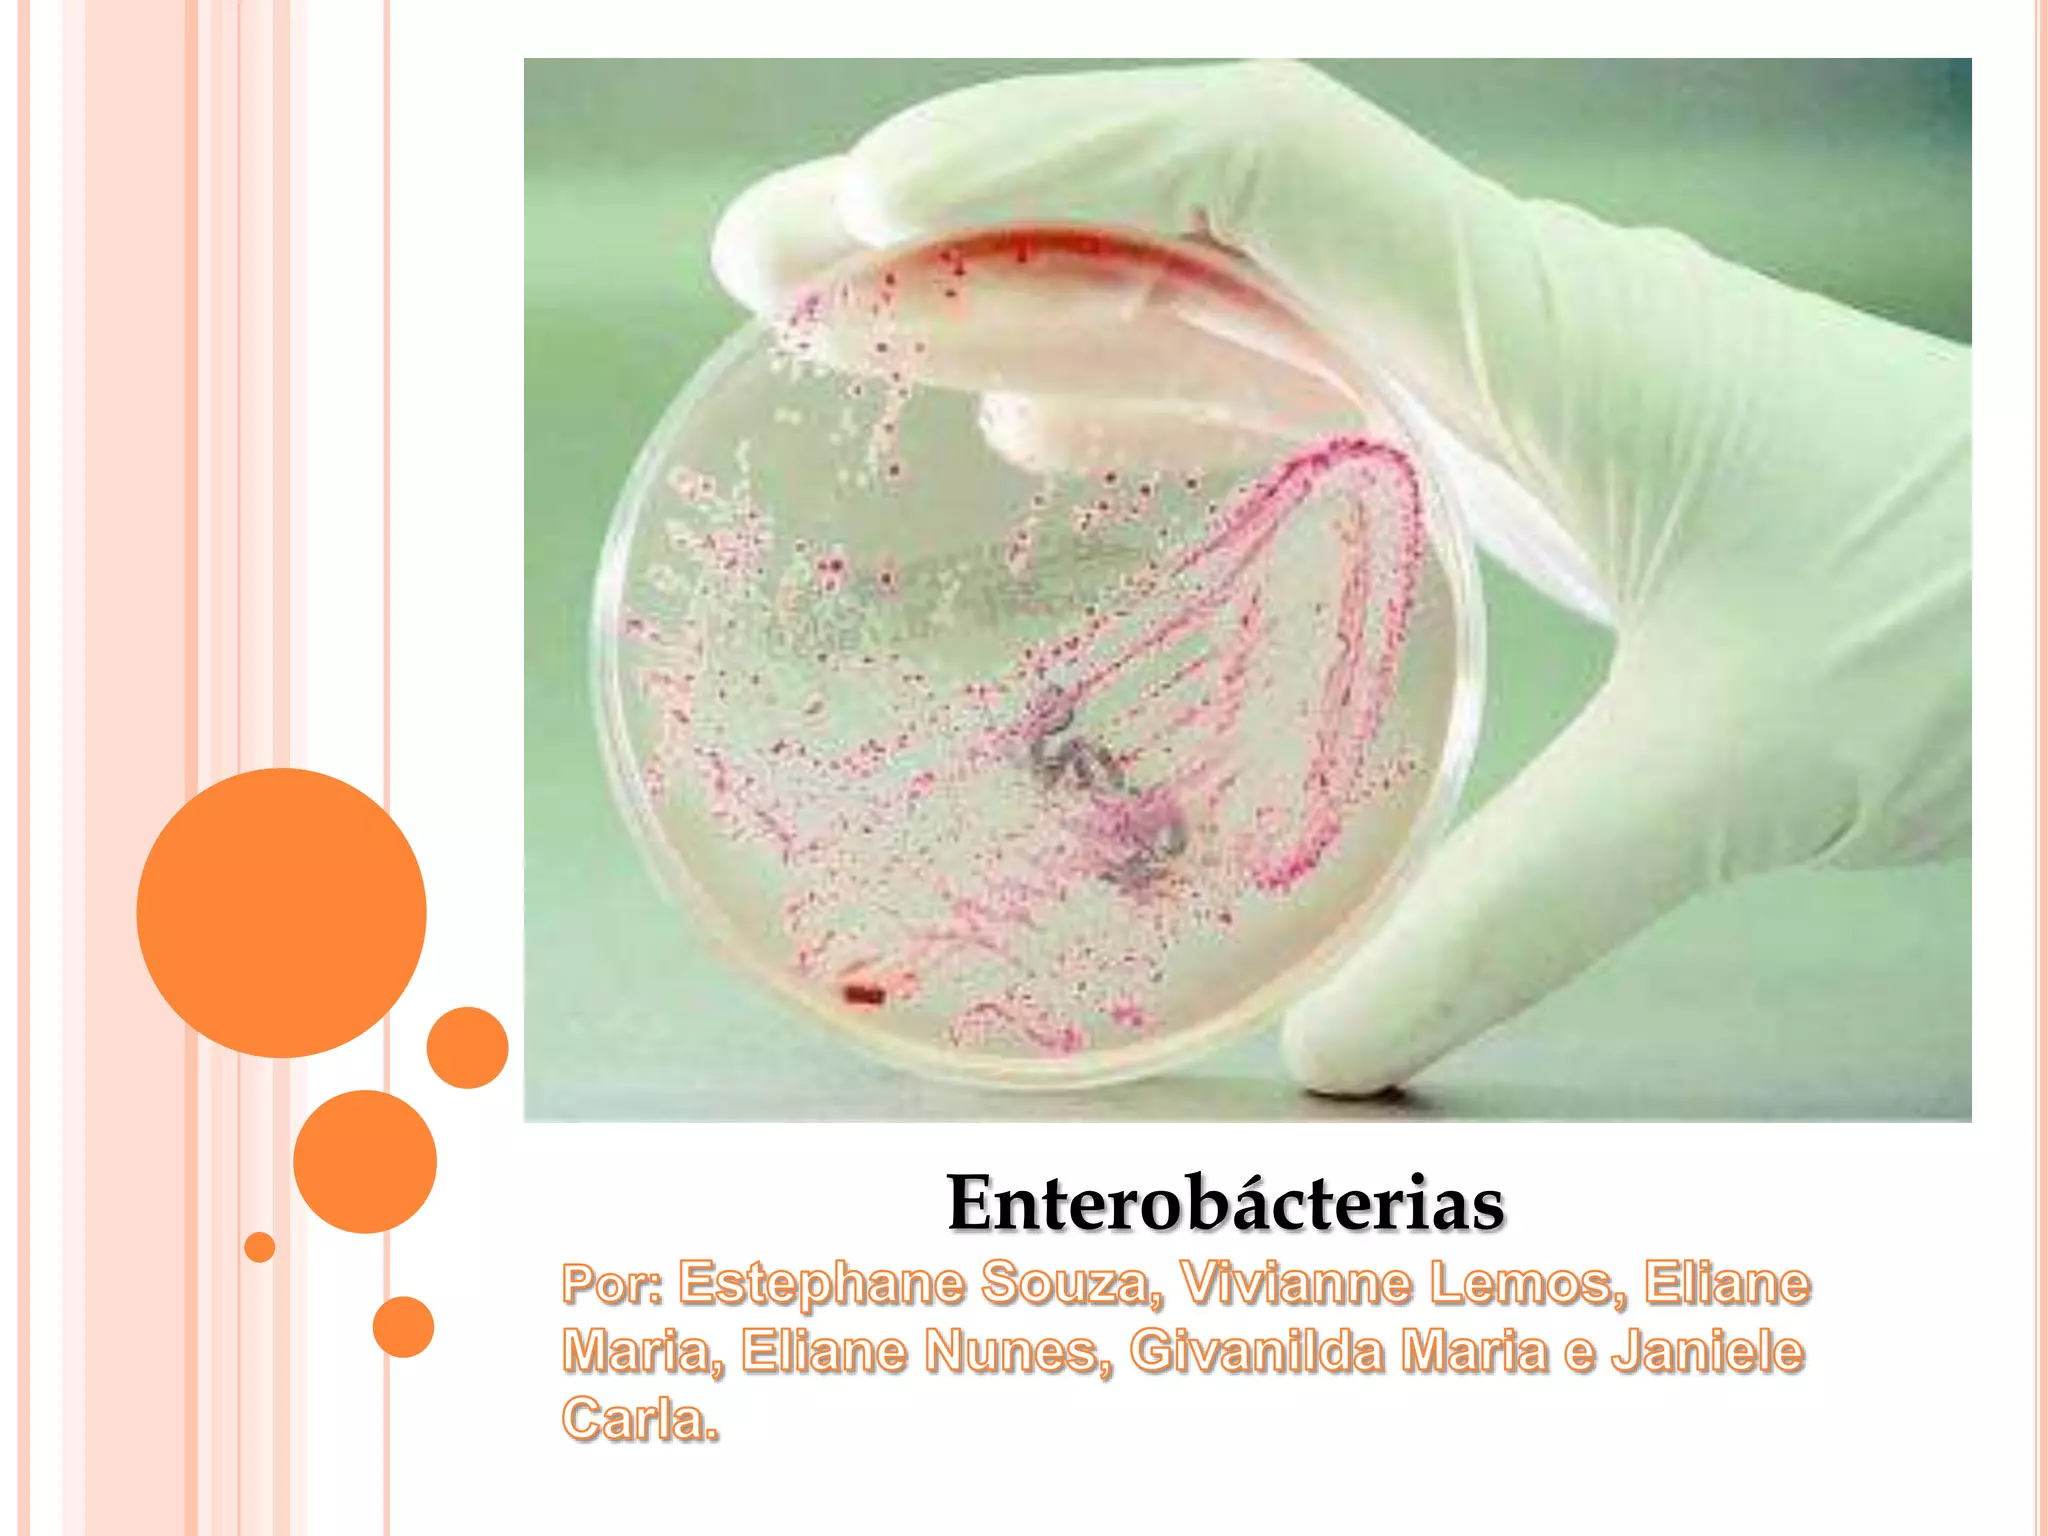

Este documento discute Enterobactérias, incluindo Escherichia coli e Salmonella. Ele fornece detalhes sobre como essas bactérias causam doenças, sintomas comuns, formas de contaminação e prevenção, além de abordar diagnóstico e tratamento. A conclusão enfatiza a importância da higiene das mãos na prevenção de infecções e epidemias causadas por essas bactérias.